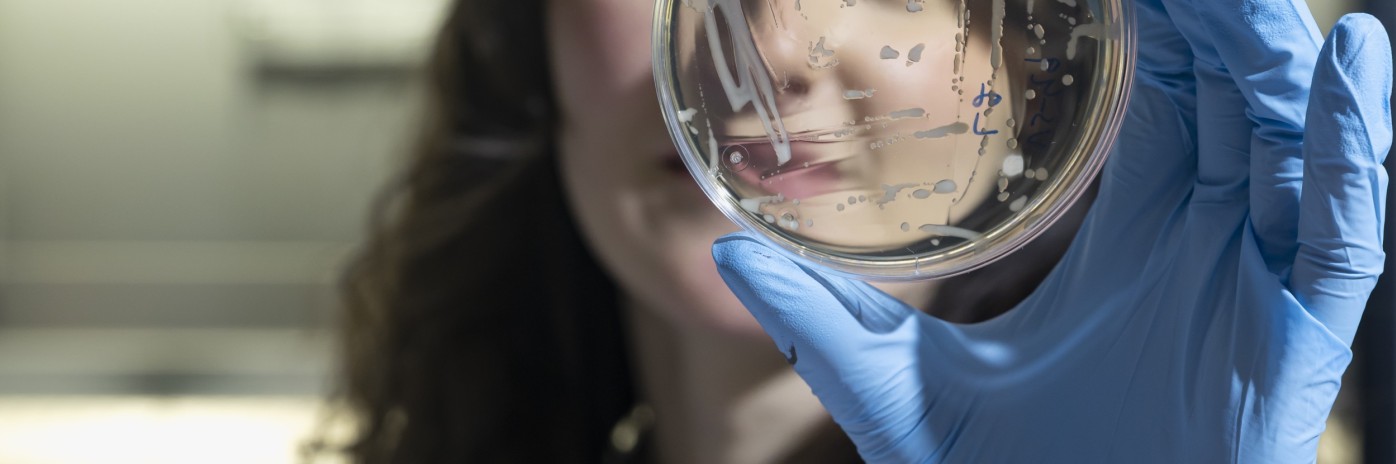

Pubblicato
20.04.2026
Dai crauti allo yogurt fino al kimchi: la fermentazione è un metodo tradizionale per la produzione di alimenti. Al NOI Techpark, la fermentazione degli alimenti diventa un campo di ricerca comune per imprese e scienza. Tre gruppi di ricerca lavorano sul tema e uniscono un know-how unico in Europa. Il centro di competenza ICOFF mette in rete queste conoscenze con piccole e medie imprese di tutta Europa e crea così il contesto per progetti ad alto valore applicativo. Nascono così nuove soluzioni che legano strettamente ricerca e applicazione – per esempio con il marchio Barilla, che sviluppa ulteriormente la fermentazione nel settore della panificazione e la rende pronta per il futuro.
Nel video scopri cosa fa ICOFF per le aziende: